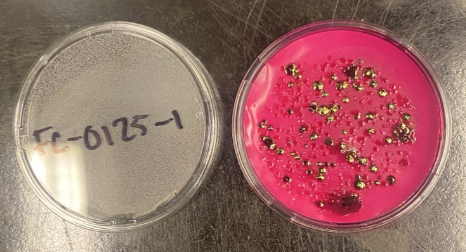

By | par Olivier Grégoire
Une version française de cet article suit la version anglaise.

This summer, I am studying the impact of extreme weather events on the water quality of Ours Creek, an important tributary of the Hurons River. Located in Montérégie, the river is labelled as having a very bad water quality in the province of Québec. I am analyzing 44 different water quality parameters, including total dissolved phosphorus, trace metals, and isotopic signatures, to better understand contaminant transport mechanisms. One of the parameters I’m focusing on is the concentration of fecal coliforms in the water, which serves as an indicator of contamination from fecal matter such as manure and sewage.
To perform the necessary biological analyses, I am collaborating with the Environmental Civil Engineering Laboratory, where I receive additional training and advice from Dr. Stephanie Loeb and her master’s student, Michelle Pelletier. Together with my colleague Seonaid, we learned a new methodology and underwent extensive safety training to handle fecal coliform samples and colonies. The methodology includes using membrane filtration to extract fecal coliforms from the river water samples, making agar dishes, and using an incubator for approximately 22 hours to let the colonies grow on the agar.
Although our initial colonies struggled to yield useful results, we adapted and refined our methodology to account for the highly variable fecal coliform concentrations. The results obtained so far reveal very high concentrations, with an average of 5300 CFU/100ml (colony-forming units per 100 milliliters of water), which is 26 times higher than the Quebec direct water use for recreation activities standard set at 200 CFU/100ml. The next steps of my research will consist of using the collected data to perform correlation analyses and graph individual rain events to better understand the concentration patterns that occurred over the summer.

******** VERSION FRANÇAISE
Cet été, j’étudie l’impact des événements météorologiques extrêmes sur la qualité de l’eau du ruisseau à l’Ours, un tributaire important de la rivière des Hurons. Située en Montérégie, cette rivière est classée parmi les cours d’eau ayant une très mauvaise qualité de l’eau au Québec. J’analyse 44 paramètres différents liés à la qualité de l’eau, dont le phosphore total dissous, les métaux traces et la signature isotopique, afin de mieux comprendre les mécanismes de transport de ces contaminants. L’un des paramètres sur lesquels je me penche est la concentration de coliformes fécaux dans l’eau. Ce paramètre peut servir d’indicateur de contamination par des matières fécales, provenant de sources telles que le purin et les rejets d’égouts.
Pour réaliser les analyses biologiques nécessaires, je collabore avec le laboratoire de génie civil environnemental, où je bénéficie de la formation et des conseils de la Dre Stephanie Loeb et de son étudiante à la maîtrise, Michelle Pelletier. Avec Seonaid, nous avons appris une méthode de laboratoire spécialisée et suivi une formation rigoureuse à la sécurité biologique, afin d’apprendre comment correctement manipuler les échantillons et les colonies de coliformes fécaux. La méthodologie comprend plusieurs étapes, notamment préparer des plats de gélose, extraire les coliformes fécaux des échantillons d’eau à l’aide d’une filtration membranaire, et utiliser un incubateur pendant 22 heures afin de permettre la croissance des colonies de coliformes.
Bien que nos premières cultures n’aient pas donné de résultats concluants, nous avons adapté et affiné notre méthodologie pour mieux tenir compte de la variabilité des concentrations en coliformes fécaux. Les résultats obtenus depuis révèlent de très hautes concentrations avec une moyenne de 5300 UFC/100ml (unités formatrices de colonies par 100 millilitres d’eau), soit 26 fois plus que le standard québécois pour l’eau destinée à des usages récréatifs à contact direct, fixé à 200 UFC /100 ml. Une fois l’expérience en laboratoire terminée, j’utiliserai les données recueillies pour effectuer des analyses de corrélation et représenter graphiquement chaque épisode de pluie, afin de mieux comprendre les variations de concentration au cours de l’été.